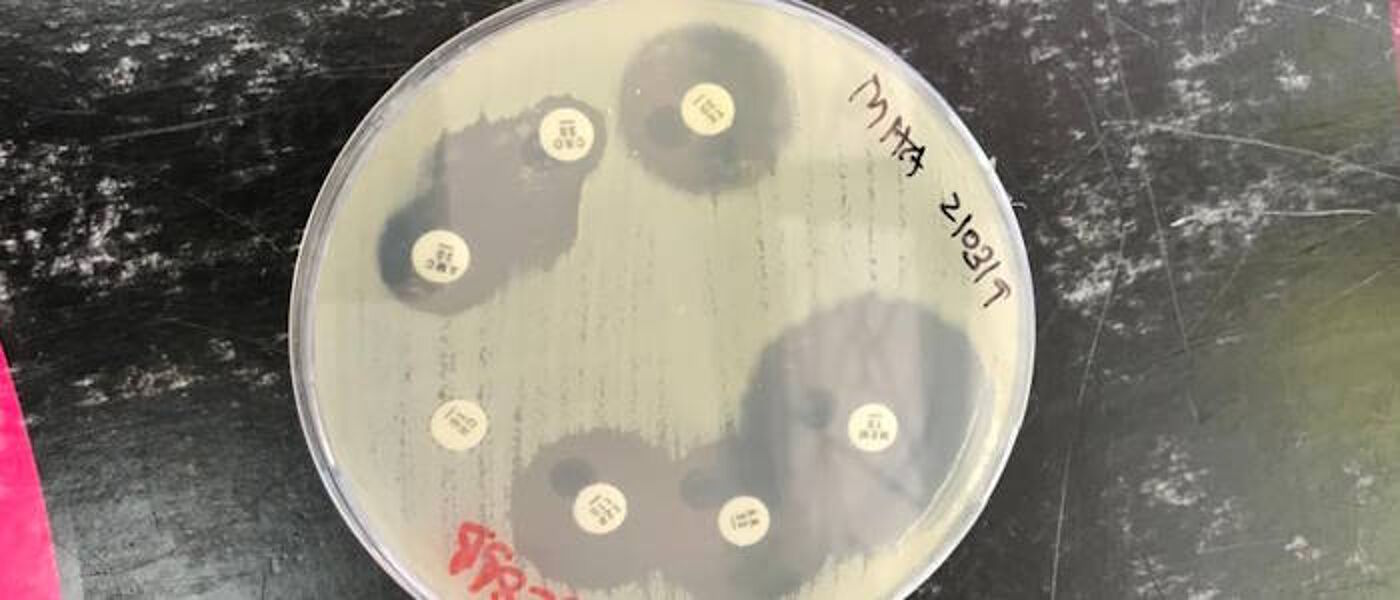

Planetary Health Projects

Evaluating the health risks of zoonotic diseases in agricultural run-off: implications for human and animal well-being
Quality of antimicrobials in East Africa along the supply chain: from the local to the global

Landscape models of AMR refugia and the impact on the evolution of resistance

The contribution of livestock movements to the spread of antimicrobial resistance in East Africa
